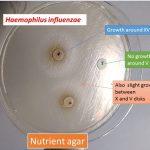
Use of V disk, X disk and XV disk for Haemophilis influenzae identification
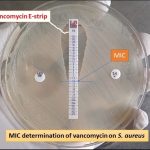
MIC of vancomycin on Staphylococcus aureus for VRSA determination

Collection Group: Clinical Bacteriology
Use of V Disk, X Disk and XV Disk for Haemophilis influenzae Identification and Its Details
Use of V disk, X disk, and XV disk for...
Use of V disk, X disk, and XV disk for...
Haemophilus influnezae Colony Characteristics on Chocolate Agar and Its Details
 Haemophilus influenzae on Chocolate agar Growth of Haemophilus influenzae on chocolate...
Haemophilus influenzae on Chocolate agar Growth of Haemophilus influenzae on chocolate...
MIC of Vancomycin on Staphylococcus aureus for VRSA Determination
MIC of vancomycin on Staphylococcus aureus for VRSA Determination The...
MIC of vancomycin on Staphylococcus aureus for VRSA Determination The...
